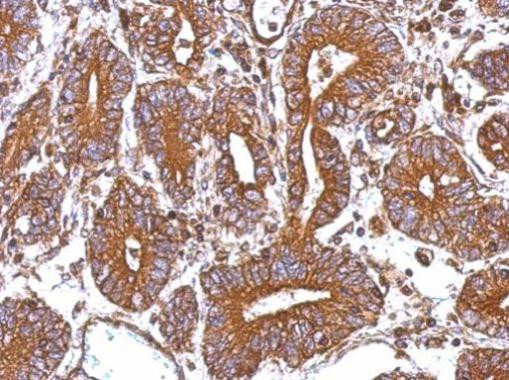
CTAGE5 Antibody in Immunohistochemistry (Paraffin) (IHC (P))

Search
Invitrogen
CTAGE5 Polyclonal Antibody
{{$productOrderCtrl.translations['antibody.pdp.commerceCard.promotion.promotions']}}
{{$productOrderCtrl.translations['antibody.pdp.commerceCard.promotion.viewpromo']}}
{{$productOrderCtrl.translations['antibody.pdp.commerceCard.promotion.promocode']}}: {{promo.promoCode}} {{promo.promoTitle}} {{promo.promoDescription}}. {{$productOrderCtrl.translations['antibody.pdp.commerceCard.promotion.learnmore']}}


Please note: We are reviewing Western blot images included in the antibody testing data in our catalog, including those provided by third parties. Unless expressly labeled or annotated as “raw-unedited”, Western blot images included in the antibody testing data in our catalog may have been edited, optimized or otherwise adjusted for presentation.
产品信息
PA5-29515
种属反应
已发表种属
宿主/亚型
分类
类型
抗原
偶联物
形式
浓度
规格
纯化类型
保存液
内含物
保存条件
运输条件
RRID
产品详细信息
Recommended positive controls: PC-3, U87-MG, SK-N-SH.
Store product as a concentrated solution. Centrifuge briefly prior to opening the vial.
靶标信息
CTAGE5/MIA-2 is a secreted cytokine, and a member of the MIA/OTOR family. Members of this family, which also includes MIA, OTOR, and TANGO, share a Src homology-3 (SH3)-like domain. MIA-2 is predominantly expressed in hepatocytes. Elevated levels of MIA-2 may represent a clinically useful marker for diagnosis of hepatic disease activity and severity.
⚠WARNING: This product can expose you to chemicals including mercury, which is known to the State of California to cause birth defects or other reproductive harm. For more information go to www.P65Warnings.ca.gov.
仅用于科研。不用于诊断过程。未经明确授权不得转售。
生物信息学
蛋白别名: CTAGE family member 5 ER export factor; Cutaneous T-cell lymphoma-associated antigen 5; Melanoma inhibitory activity protein 2; Meningioma-expressed antigen 6/11; MIA protein 2
基因别名: CTAGE5; MEA11; MEA6; MGEA11; MGEA6; MIA2
Entrez Gene ID: (Human) 4253